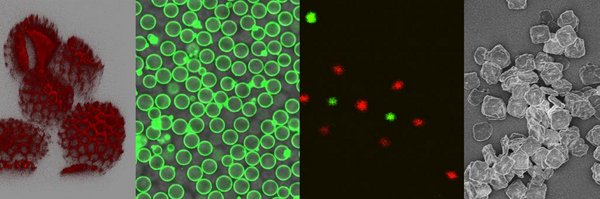
TheColloid Profile Banner

Kuehne Lab
@TheColloid
Followers
207
Following
100
Media
20
Statuses
86
⌬♡
Ulm University, Deutschland
Joined July 2014
Photostable Triphenylmethyl-Based Diradicals with a Degenerate Singlet-Triplet Ground State and Strong Photoluminescence
pubs.rsc.org
We present a new class of luminescent diradicals based on tris(trichlorophenyl)methyl (TTM) cores symmetrically bridged by indolocarbazole donors. These diradicals exhibit pure diradical character y0...
0
1
7
Something special to finish off my trip in San Diego, having an omakaze meal with @GroupKaji and @TheColloid.
0
2
25
Second lunch day of tacos, this one at Lola 55. A little bit of a trek but so worth it. Thanks @TheColloid for the recommendation.
0
1
8
What a night hanging out with @TheColloid and sharing a crawfish boil and then watching the end of the Padres game from the rooftops bar of the Marriott (we couldn’t get into the park unfortunately).
0
1
12
My first street taco extravaganza, at City Tacos, thanks to @TheColloid for both the suggestion and for the company. Can’t wait for the next place.
0
1
13
Hanging out at a brew house with @TheGatherLab @TheColloid @MurawskiLab Pauline and Sonny. Had a pretty tasty burger and shared these pretzel bites.
0
2
16
Lunch with friends @Perepichkagroup, @Besserchemistry, Ori and @TheColloid on the first day of #isna20. Getting my fix in of spicy pulled noodles and happy to also share with Alex his Dan Dan noodles.
0
1
35
Santa 🎁 brought our 1st paper in @Chem_CP! We show that chemically-driven acylphosphate reaction networks and optical wellplate screenings have a great chance of becoming mainstay tools of SysChem. @englert_andreas, @JannikSchiessl with: @TheColloid OA: https://t.co/M9qf2utITi
6
21
117
Check out our latest work with Kuehne lab @TheColloid out in @AdvOpticalMat
@Uni_WUE @uni_ulm @fangyuan_zfy Aza[7]helicene Functionalized Triphenylmethyl Radicals with Circularly Polarized Doublet Emission A https://onlinelibrary.wiley.com/doi/10.1002/adom.202301707
9
16
133
Varying the Stiffness and Diffusivity of Rod-Shaped Microgels Independently through Their Molecular Building Blocks (Laura De Laporte and co-workers) @DeLaporte_Lab @TheColloid #openaccess thanks to #projektDEAL
onlinelibrary.wiley.com
Currently, it is not yet fully understood how the polymer composition influences the internal structure of microgels and how this affects specific biomedical applications. We reveal how the archite...
0
2
5
Would you like to work with #artificialcells #DNA #3Dprinting #hydrogels or #neuromorphic computing in an international and interdisciplinary team? We have openings for 2 Postdoc and 1 PhD Position: https://t.co/rek1jyQcri
https://t.co/hPvZZNEk9Q
https://t.co/p4IlhqOvjA RT=💕
3
45
111
Check out our nanohoop polymers incorporating antiaromatic dibenzopentalenes and how they show improved battery performance in @angew_chem. Congrats to @PhilippSeitz1 who synthesized them! @ClusterPolis @ulm
https://t.co/GWULL8snQ0
1
9
65
Short escape from #acsfall2023 to the redwoods and Golden Gate Bridge with @goestlich @TheColloid such beautiful trees. I ❤️ 🌲 #workworkbalance
0
2
25
Nature "chose phosphates" for very good reasons. Systems chemists, check out our preprint on a robust and versatile acylphosphate reaction cycle! Transient excimers enabled well plate screenings to rapidly optimize catalysis (with @TheColloid) 👏 https://t.co/CLO7lmLeKw
0
3
74
Mona's Paper "On the Effect of Donor Strength on the Photoluminescence Performance in Mono-substituted N-Donor Triarylmethyl Radicals" is out on @ChemRxiv - https://t.co/DpWimOsW1g check it out!
0
1
8
Strong coupling enables efficient microcavity #OLED with stable colors across a wide range of angles. Check our paper by @andreas_physics in @NaturePhotonics: https://t.co/pbaS1rVLBp. Really relevant for the #display and #OLEDTV industry, I think. @ChemUniCologne @univofstandrews
Coupling light and matter to ensure optimum brightness for displays @univofstandrews @NaturePhotonics
3
2
39
Andreas' paper on melt-processable and carbonizable PAN is out! Very cool. #carbon #carbonfiber #3Dprinting #supercap #electrode Switchable Polyacrylonitrile‐Copolymer for Melt‐Processing and Thermal Carbonization ...
0
1
9
Autonomous Soft Robots empowered by Chemical Reaction Networks fresh in Advanced Materials. Congrats to Giorgio and @Daniele_DelG w/ DiStefano Lab. 🇮🇹🇮🇹🇮🇹🇩🇪🇩🇪 https://t.co/pa7uYZTIM7
#eufunded @creanet_ITN @AdvSciNews #softrobotics #noneqsys
3
11
107
Record low threshold polariton lasers using alignment and beta-phase in a conjugated polymer. 1st paper from our new HCNB lab @ChemUniCologne. Just >1yr after labs came online. Is this fast or slow? Thx Florian Le Roux, @andreas_physics & Donal Bradley.
advanced.onlinelibrary.wiley.com
Aligning poly(9,9-dioctylfluorene) as the active layer on top of a thin sulfuric dye 1 photoalignment layer and then generating 15% β-phase conformation enables observation of anisotropic polariton...
0
5
12